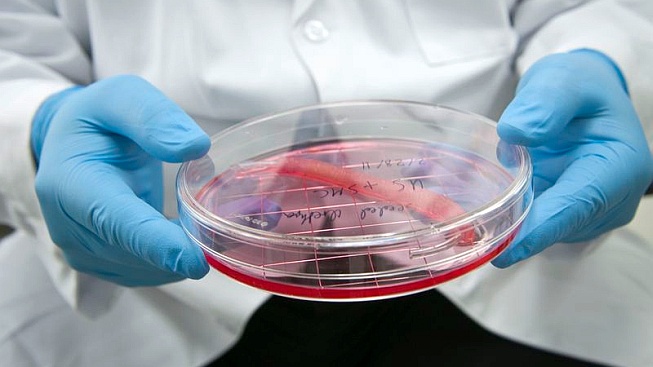
Výzkumníci hlásí průlom na cestě k pěstování orgánů v laboratoři

Výzkumníci hlásí průlom na cestě k pěstování orgánů v laboratoři
17. 6. 2015 – 13:00 | Technologie | Jan Toman |Diskuze:
Ztráta či vážné poškození životně důležitého orgánu ještě donedávna končilo bez výjimky smrtí. A v případě, že k životu nezbytný nebyl, vedlo obvykle k výraznému snížení kvality života.
Obrovský pokrok můžeme vystopovat od padesátých let, kdy byly provedeny první úspěšné transplantace orgánů od cizích dárců. Tato procedura zachránila miliony životů, ale pořád má svá omezení.
Tělo nemusí cizí tkáň přijmout a pacient je nucen užívat léky k potlačení své imunity. Ani náhrady specializovanými přístroji se neobejdou bez problémů. I přes obrovský pokrok v této oblasti nedokáží obstarat většinu funkcí daných orgánů, například končetin.
Zatím nedosaženým „svatým grálem“ zůstává vypěstování dokonalé kopie orgánu přímo z buněk pacienta. Ďábel se totiž skrývá v detailu. Získat buňky schopné změny ve specializované typy a vypěstovat z nich v laboratoři kus kůže nebo jednolité tkáně není zas tak velký problém. Daleko těžší je vytvořit funkční orgán se složitou vnitřní stavbou.
Největší výzvou je pak vytvořit kopii celé části těla. Buňky schopné vytvářet potřebné tkáně totiž potřebují nějaké „lešení“, na kterém můžou růst. Velmi důmyslné řešení tohoto problému nedávno publikoval tým předních medicínských výzkumníků na příkladu končetiny potkana.
Uvědomili si, že vůbec nejlepší lešení nám poskytla příroda – orgán samotný. Problém spočívá jen v tom, že už je obsazený původními buňkami. Ty však můžeme zničit. Stačí cévy propláchnout směsí chemikálií, která je rozloží, ale okolní mezibuněčnou hmotu zachová.
Následně experimentátoři na správná místa vložili buňky schopné se změnit ve svaly, kosti a cévy, a nechali je růst. Občas sice museli zasáhnout, například vyslat elektrický impuls, aby se svaly dostatečně vyvinuly, ale výsledek předčil všechna očekávání. Staronová končetina byla téměř dokonalá.
Přesto není celá procedura zatím bez chyby: podobně jako u transplantací od cizích dárců je například velmi obtížné připojit končetinu na nervy. Vývoj v této medicínské oblasti ale běží plným tempem a i tady se začíná blýskat na lepší časy.
Zdroj: BJ Jank, L Xiong, PT Moser, JP Guyette, X Ren, CL Cetrulo, DA Leonard, L Fernandez, SP Fagan & HC Ott (2015): Engineered composite tissue as a bioartificial limb graft. Biomaterials 61. s 246-256.